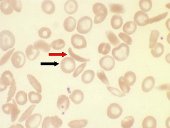
Image

Krankheitsformen: Welche Arten der Sichelzellkrankheit gibt es?
Autor: PD Dr. med. Gesche Riabowol, Redaktion: Ingrid Grüneberg, Freigabe: Dr. med. S. Lobitz, Dr. med. R. Dickerhoff, Prof. Dr. med. U. Creutzig, Zuletzt geändert: 06.05.2024 https://kinderblutkrankheiten.de/doi/e100583
Es gibt verschiedene Formen der Sichelzellkrankheit. Diese werden verursacht durch eine jeweils andere Veränderung in der Erbanlage (Gen) für den roten Blutfarbstoffs (Hämoglobin). Alle Formen werden vererbt und können Schmerzkrisen und Organschäden erzeugen, jedoch verlaufen manche schwerer als andere. Die drei häufigsten Formen sind:
- die Sichelzellkrankheit HbSS
- die Sichelzellkrankheit HbSβ-Thal
- die Sichelzellkrankheit HbSC
Die SCD-S/S ist die häufigste und am schwersten verlaufende Form. Kinder mit SCD-S/S haben jeweils ein krankes Gen für das Hämoglobineiweiß von beiden Elternteilen geerbt. Sie bilden nur das krankhaft veränderte Sichelzellhämoglobin (HbS).
An der SCD-S/beta-Thal. erkranken Kinder, die von einem Elternteil das Sichelzell-Gen und vom anderen ein Gen für eine Beta-Thalassämie erhalten haben. Die Beta-Thalassämie ist eine andere Bluterkrankung, bei der zwar kein verändertes Hämoglobin gebildet wird, dafür aber zu wenig (+) oder gar keines (0). Bei verringerter Hämoglobinbildung durch das Thalassämie-Gen heißt die Krankheit Sichelzellkrankheit SCD-S/ß+Thal. Ihr Verlauf ist meist weniger schwer als der einer SCD-S/S. Das Erscheinungsbild der Sichelzellkrankheit SCD-S/0-Thal ist aber mit dem der SCD-S/S (nicht aber mit einer Thalassämie) vergleichbar.
Bei der SCD-S/C-Krankheit vererbt ein Elternteil das Sichelzell-Gen, während der andere ein ebenfalls verändertes Hämoglobin-Gen, das HbC-Gen, an das Kind weitergibt. Die Patienten haben meist sehr hohe Hämoglobinwerte, die einerseits von Vorteil sind (bessere körperliche Leistungsfähigkeit) andererseits, weil das Blut sehr dickflüssig ist, zu Komplikationen führen. Die SCD-S/C-Form der Sichelzellkrankheit zeigt in der Regel weniger schwere Verläufe als die SCD-S/S. Sie kann aber trotzdem mit schweren gesundheitlichen Problemen wie dem Risiko der Erblindung (Erkrankungen der Netzhaut) und der Ertaubung (Innenohrschäden durch hohe Hämoglobinkonzentrationen) einhergehen.
Die Sichelzellkrankheit entwickelt sich also nicht nur dann, wenn ein Kind zwei Sichelzell-Gene erbt, sondern auch, wenn ihm ein Sichelzell-Gen kombiniert mit einem anderen krankhaft veränderten Hämoglobin-Gen (wie dem HbC- oder dem Thalassämie-Gen) vererbt wurde.